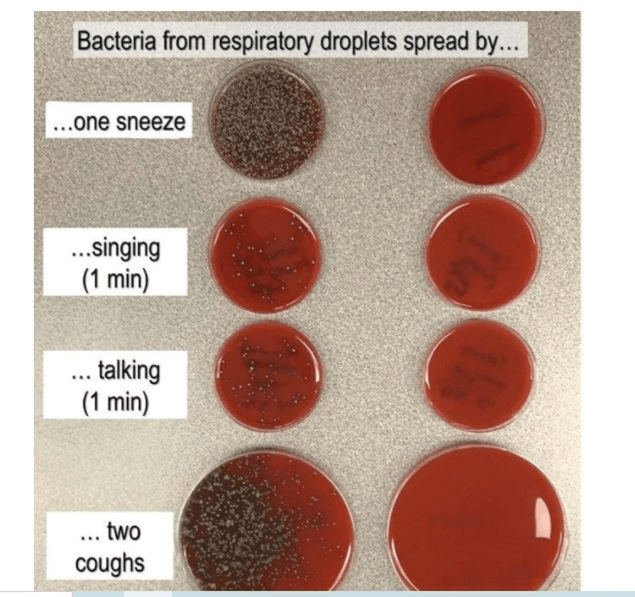

As of 10:30, I have only slept one hour in the last twenty-four, and it has not been this cliff-hanger of an election that has me wandering around like Marley’s ghost.
I call it Restless leg Syndrome; the doctors call it Idiopathic Muscle Spasms. Whatever name it goes by, it makes sleeping impossible. When I go to bed – or sit still for too long, for that matter – my legs begin to jerk uncontrollably, and then the rest of my body joins the party. My torso curls, my head moves around, and my hands will begin to flex. Over the years, I’ve taken umpteen different anticonvulsants and Parkinson meds, most of which work fine for a while, and then some sort of dreadful side effect starts up.
Can you say, “Maddening”?
Last night I took my medicine around 9:00, and went upstairs a little after 10 PM to find the cat was there before me. OK, the cat can stay if he curls up at the foot of the bed. I moved Eddie to his designated spot and slid between the covers myself. The resident feline decided he did not want to sleep by himself, but proceeded to walk up my body and sit on my chest. I shoved him rather unceremoniously to one side, and he snuggled up on the pillow, leaning against my head.
And decided to take a nice long bath.
I shoved him out the door and climbed back into bed, only to discover that my medicine had not taken hold, and I was all over the place. I figured I hadn’t waited long enough, so I went back downstairs, cleared the dining room table, and put on a fresh tablecloth. About a year or so ago we got rid of our old work-horse of a table and replaced it with an oval solid cherry model. Now I have no tablecloths that actually fit, and I am OCD enough that this drives me bonkers. I got a ruler and measured how far this cloth hung over on each side – six inches – and then pulled the cloth toward me until the far end was also hanging over six inches. Next step was the measure the long end that was hanging nearly to the floor, mark it a half foot, pull the cloth off, fold it in half and draw the proper radius with a yardstick and a washable pen. The kitchen scissors won’t cut fabric, and The Squire was sawing wood, oblivious to my thrashing around, so I just put the cloth back on the table. I’ll finish it today.
Another trip to the bedroom, and I’m still twitching, so I got up AGAIN and made a pot of corn chowder. Peeled potatoes, chopped onions, yada, yada, and got it going, then took the compost out to the back of the lot, and swept and “Swiffered” the kitchen floor. I took another pill at 2:30, and wandered back to bed at 3:30 this morning. At 5:00 I gave up completely, took a shower and got dressed.
The Squire left around 8:30 to see a doctor about that sore shoulder, so I went upstairs again and slept for an hour. Aaargh!